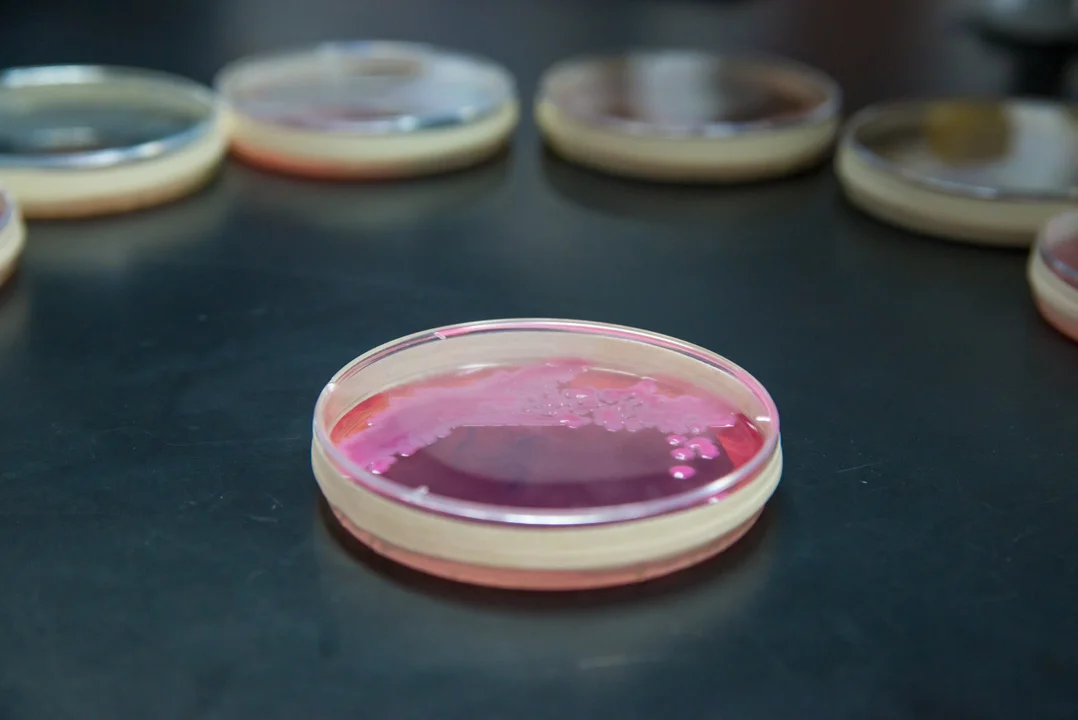

W odpowiedzi na wykrycie przypadków zakażenia New Delhi, Szpital Miejski im. J. Strusia w Poznaniu wprowadził tymczasowe ograniczenia odwiedzin na oddziale wewnętrznym.
W związku z wykryciem pojedynczych przypadków Klebsiella pneumoniae NDM (New Delhi) antybiotykoopornych , wprowadzamy tymczasowe ograniczenia dotyczące odwiedzin na oddziale wewnętrznym - informuje w mediach społecznościowych poznańskich szpital.
Ograniczenia mają na celu zapobieganie rozprzestrzenianiu się antybiotykoopornych bakterii.
Czym jest NDM, jak się przenosi i dla kogo stanowi zagrożenie?
NDM to bakterie naturalnie występujące w jelitach człowieka. Klebsiella pneumoniae NDM stała się odporna na większość antybiotyków, w tym karbapenemy, przez częste stosowanie ich w leczeniu ciężkich zakażeń.
Bakterie NDM rozprzestrzeniają się w szpitalach i domach opieki przez bezpośredni kontakt z nosicielem. Mogą przenosić się zarówno drogą kropelkową, pokarmową, jak i poprzez kontakt z zanieczyszczoną powierzchnią.
W większości przypadków są obecne w jelitach bez objawów, ale mogą wywołać zakażenia u osób z osłabioną odpornością - np. poddawanych chemioterapii.
Jakie są objawy zakażenia New Delhi?
Zakażenie New Delhi można pomylić z grypą, bo bo daje podobne objawy:
- kaszel i duszności oraz ból w klatce piersiowej,
- wysoką gorączkę,
- zawroty głowy,
- dreszcze,
- ból mięśni,
- ogólne osłabienie.
Czy można pozbyć się bakterii NDM?
Bakterii NDM nie da się usunąć z organizmu - leczy się tylko zakażenia przez nie wywołane, takie jak zakażenia dróg moczowych czy rany chirurgicznej. Nosicielstwo trwa kilka miesięcy, ale najczęściej ustępuje w ciągu pół roku, co potwierdzają badania wymazu z odbytu oraz testy genetyczne.
New Delhi w Poznaniu. Jakie ograniczenia wprowadził szpital przy Szwajcarskiej?
W odpowiedzi na wykrycie bakterii NDM, Szpital Miejski im. J. Strusia w Poznaniu wprowadził następujące ograniczenia dotyczące odwiedzin na oddziale wewnętrznym:
- zakaz wstępu na oddział osób z objawami infekcji górnych dróg oddechowych,
- maksymalnie jedna osoba przy łóżku chorego,
- odwiedziny tylko w godzinach 12:00 - 13:00 oraz 16:00 - 17:00.
Dodatkowe ograniczenia dotyczą pacjentów przebywających w izolatkach:
- wejście na salę możliwe maksymalnie na 5 minut,
- przed wejściem do sali należy ubrać rękawiczki jednorazowe oraz fartuch jednorazowy.
PRZECZYTAJ TAKŻE: Co zabiło ryby w Kanale Bernardyńskim w Kaliszu? Są wstępne ustalenia

Komentarze (0)